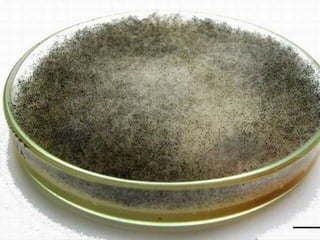
©drseshasai
Culture

The document provides a comprehensive overview of mucormycosis, an opportunistic infection primarily affecting immunocompromised individuals. It details the causes, clinical features, diagnostic methods, treatment options, and prognosis of the disease, emphasizing the importance of early diagnosis and intervention. The document also highlights various antifungal therapies, the role of surgery, and challenges in management, particularly in patients with hematological malignancies.